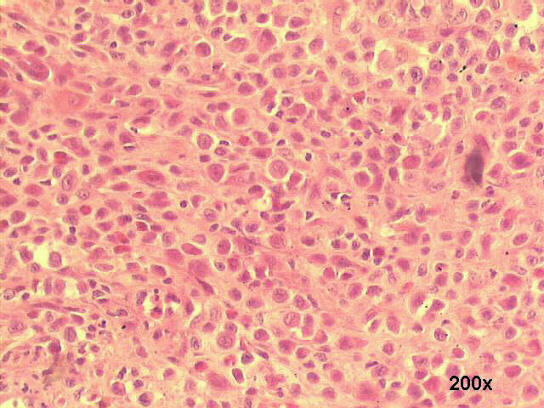

Lymph
node biopsy, H&E staining
Morphology
of Langerhans' cells is characterisitic: histiocytes with convoluted
nuclei with longitudinal grooves. EM images of the histiocytes will
show the typical Birbeck's granules or "zippers". Eosinophils are
frequent but not necessary for the diagnosis. Immunohistochemical
studies are very useful, the Langerhans' cells being positive for
CD1a, S100, OKT6, and HLA-DR antibodies.
In 1868 Paul Langherans described dendritic cells in the human epidermis. Later, they were described in lung, thymus, and in the lamina propria of all mucosae. They derive, together with monocytes, from stem cells in the bone marrow, and migrate to the above mentioned organs, where they play a critical role in antigenic presentation and T cell activation. Langherans cell histiocytosis is an abnormal accumulation of Langherans cells in some tissues. The localized solitary (usually in a bone) lesion is called eosinophilic granuloma or histiocytosis X. The Hand-Christian-Schüller syndrome is characterized by multiple bone lesions, exophtalmus and diabetes insipidus. The acute fulminant disease is called Letterer-Siwe's disease.
Hospital de Clinicas de Porto Alegre, Pathology & Cytopathology
Laboratories
Porto Alegre,
RS Brazil